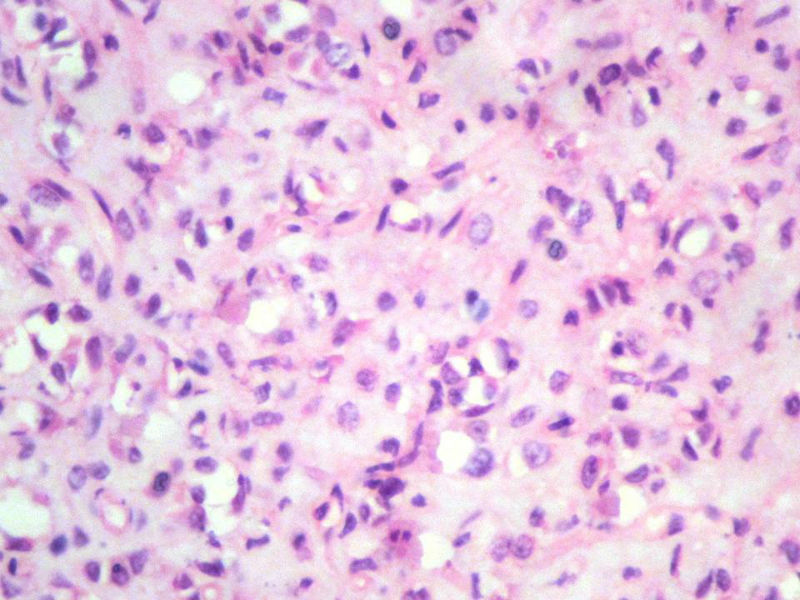
右股骨上段皮下肿物，新加免疫组化图11
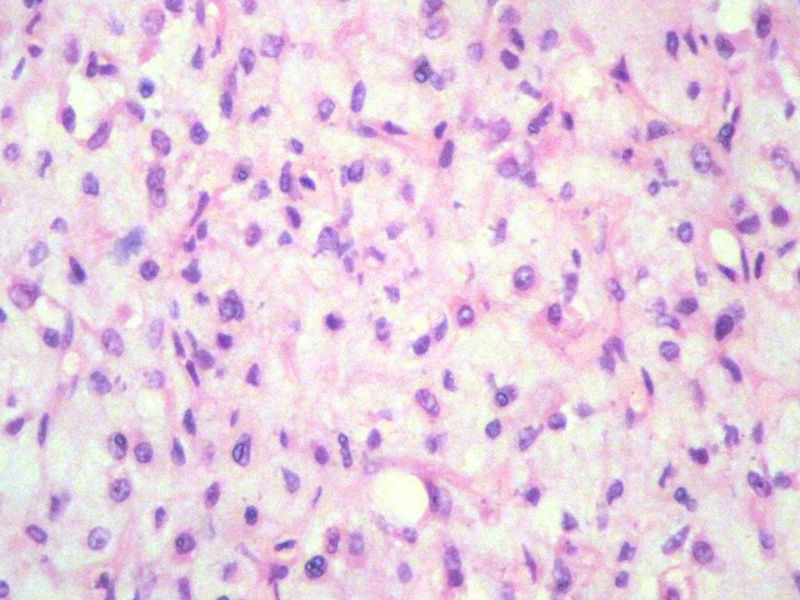
右股骨上段皮下肿物，新加免疫组化图13
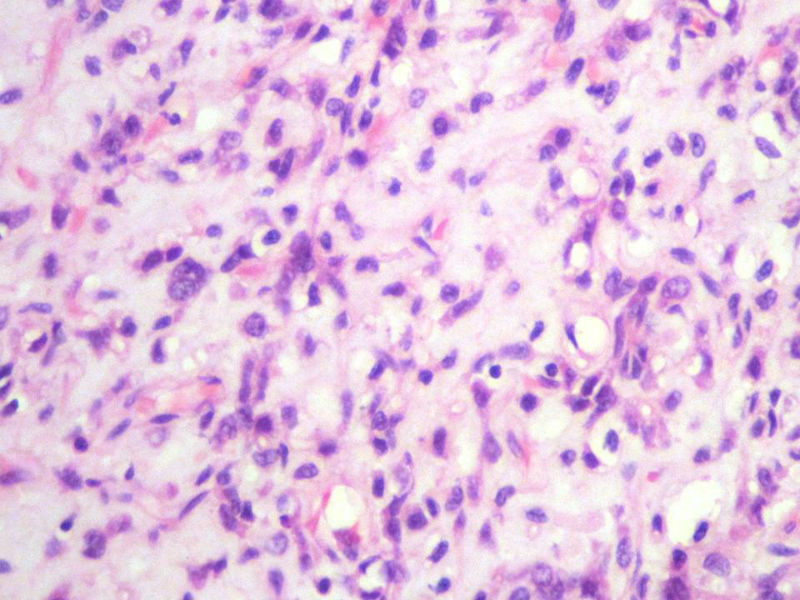
右股骨上段皮下肿物，新加免疫组化图14
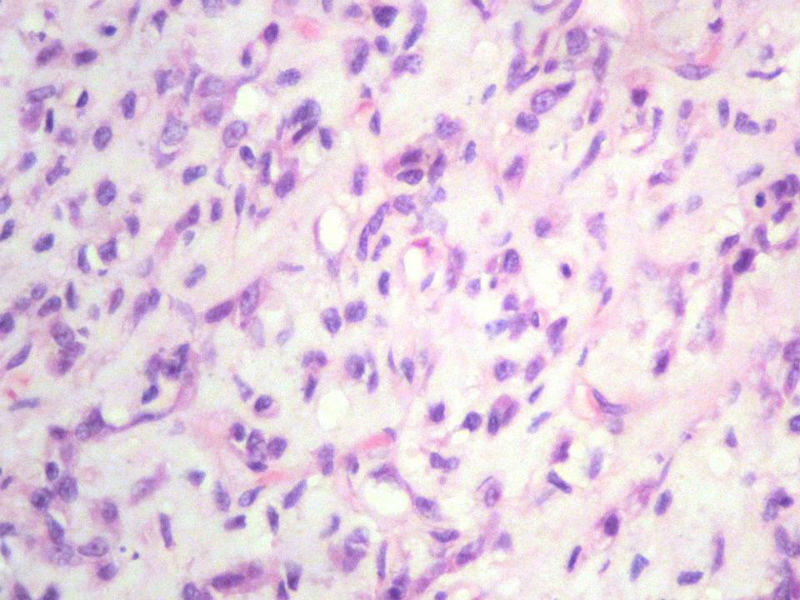
右股骨上段皮下肿物，新加免疫组化图15
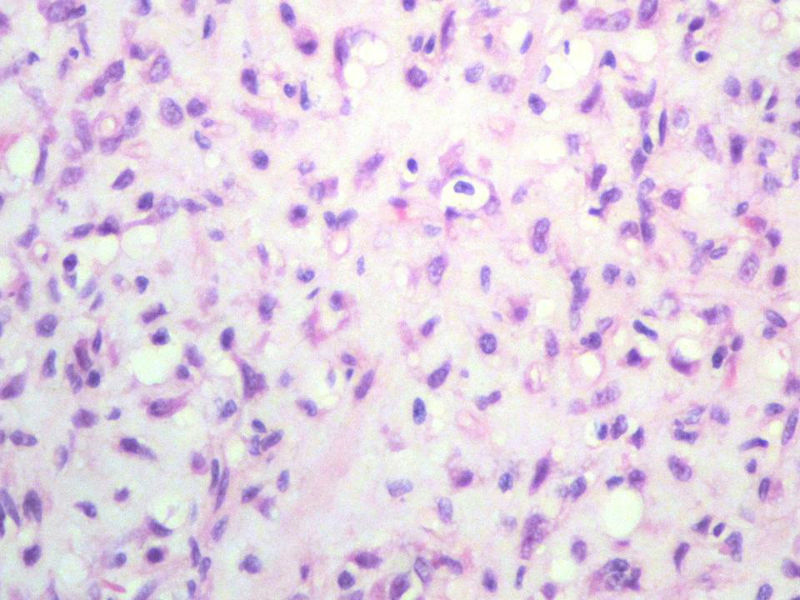
右股骨上段皮下肿物，新加免疫组化图16

| 图片: | |
|---|---|
| 名称: | |
| 描述: | |
- 右股骨上段皮下肿物,新加免疫组化
男,27岁,右股骨上段皮下肿物1年余,无明显疼痛,检查肿物明显隆起于皮下,边界清楚,手术完整切除肿物。肉眼,肿物6X6X5厘米,外观多结节状,似有包膜,切面灰白色,质韧。
特别提示:镜下核分裂3-4/HP.

名称:图1
描述:幻灯片2

名称:图2
描述:幻灯片3

名称:图3
描述:幻灯片4

名称:图4
描述:幻灯片5

名称:图5
描述:幻灯片6

名称:图6
描述:幻灯片7

名称:图7
描述:幻灯片8

名称:图8
描述:幻灯片9

名称:图9
描述:幻灯片10

名称:图10
描述:幻灯片11
名称:图11
描述:幻灯片12

名称:图12
描述:幻灯片13
名称:图13
描述:幻灯片14
名称:图14
描述:幻灯片15
名称:图15
描述:幻灯片16
名称:图16
描述:幻灯片17
-
本帖最后由 xclbljys 于 2011-11-10 17:20:32 编辑

- 许春雷
-
chenliu0552 离线
- 帖子:502
- 粉蓝豆:22
- 经验:985
- 注册时间:2010-12-10
- 加关注 | 发消息
-
binghongcha 离线
- 帖子:311
- 粉蓝豆:452
- 经验:334
- 注册时间:2011-08-02
- 加关注 | 发消息
-
chenliu0552 离线
- 帖子:502
- 粉蓝豆:22
- 经验:985
- 注册时间:2010-12-10
- 加关注 | 发消息
-
本帖最后由 chenliu0552 于 2011-11-11 19:41:22 编辑
感谢xclbljys 老师一如既往提供好病例!本例CD34、S100、CGA结果用血管或脂肪源性肿瘤解释有一定困难。xclbljys 老师的考虑很有道理,首先能考虑到标记CGA就很厉害了。但我个人尚有一些不明白之处,还请多指点:
1.一定是恶性吗?Ki67或其它标记?
2.临床资料支持吗?如年龄,肿瘤位置深浅,切面,放射学检查等。
3.HE: 1)肿瘤细胞的形态、排列方式;2)间质和血管特点等?
4.组化:1)其它的神经内分泌标记如Syn, NSE? CK?
2)CGA的结果是排除脂肪源性肿瘤或其它肿瘤的有力证据吗?
-
chenliu0552 离线
- 帖子:502
- 粉蓝豆:22
- 经验:985
- 注册时间:2010-12-10
- 加关注 | 发消息
-
binghongcha 离线
- 帖子:311
- 粉蓝豆:452
- 经验:334
- 注册时间:2011-08-02
- 加关注 | 发消息
-
epithelial 在线
- 帖子:239
- 粉蓝豆:24
- 经验:275
- 注册时间:2008-08-22
- 加关注 | 发消息
回答chenliu0552 网友提问:
1. 本例没有做KI-67,但我在前面特别提示:镜下核分裂3-4/HP.
2.临床资料如前所示。
3. 本例组织学改变与粘液性脂肪肉瘤,粘液样纤维肉瘤,纤维粘液样肉瘤,骨外粘液样软骨肉瘤都有重叠之处,且镜下并未见典型结构。由此,免疫组化结果就尤显重要。特别是专业书籍提到,突触素或嗜铬素阳性,对鉴别诊断有重要意义。我用CGA,也是在以上几个肿瘤中举棋不定而为。NSE和CK没用,其实我想用更多的抗体来证实更多的东西,但患者的经济条件不太好,遗憾!
看看我们病理科的特色出来了吧?呵呵,多凄凉啊,科室针对好的病例,是不是应该支持自费染色证实一下呢?仅仅是为了学习这个钱也是值得的吧,老师您说呢?










































